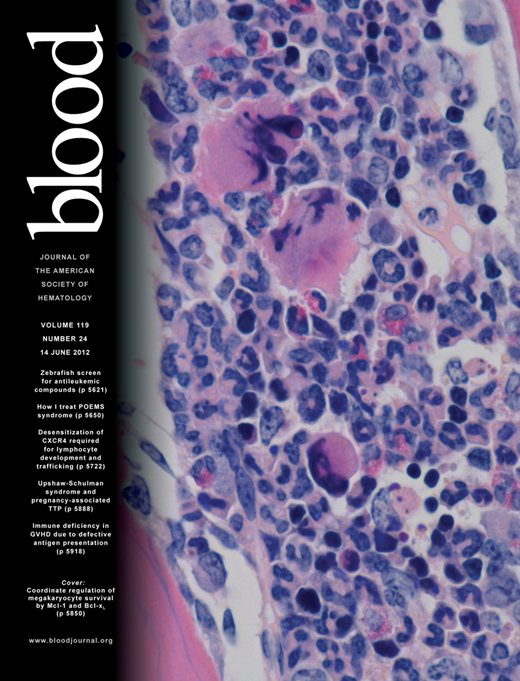

Abstract
The pathogenesis of hepatosplenic T-cell lymphoma (HSTL), a rare entity mostly derived from γδ T cells and usually with a fatal outcome, remains largely unknown. In this study, HSTL samples (7γδ and 2αβ) and the DERL2 HSTL cell line were subjected to combined gene-expression profiling and array-based comparative genomic hybridization. Compared with other T-cell lymphomas, HSTL had a distinct molecular signature irrespective of TCR cell lineage. Compared with peripheral T-cell lymphoma, not otherwise specified and normal γδ T cells, HSTL overexpressed genes encoding NK-cell–associated molecules, oncogenes (FOS and VAV3), the sphingosine-1-phosphatase receptor 5 involved in cell trafficking, and the tyrosine kinase SYK, whereas the tumor-suppressor gene AIM1 (absent in melanoma 1) was among the most down-expressed. We found highly methylated CpG islands of AIM1 in DERL2 cells, and decitabine treatment induced a significant increase in AIM1 transcripts. Syk was present in HSTL cells and DERL2 cells contained phosphorylated Syk and were sensitive to a Syk inhibitor in vitro. Genomic profiles confirmed recurrent isochromosome 7q (n = 6/9) without alterations at the SYK and AIM1 loci. Our results identify a distinct molecular signature for HSTL and highlight oncogenic pathways that offer rationale for exploring new therapeutic options such as Syk inhibitors and demethylating agents.
Introduction
Hepatosplenic T-cell lymphoma (HSTL), originally described as hepatosplenic γδ T-cell lymphoma, is a rare lymphoma entity with a peculiar clinical presentation (hepatosplenomegaly without significant lymphadenopathy) and pathologic features (intrasinusal/sinusoidal infiltration by neoplastic Τ cells in the BM, spleen, and liver).1-3 The disease occurs predominantly in young adults, in association with a setting of long-term immunosuppression in solid organ transplantation recipients or with prolonged antigenic stimulation.4 Cases have also been reported in children treated by azathioprine and infliximab for Crohn disease.5 Whereas most HSTL cases are derived from the γδ subset, a few similar cases with an αβ phenotype have also been described,6,7 and the simplified designation “hepatosplenic T-cell lymphoma” was favored in the latest World Health Organization (WHO) classification.8 HSTL is associated with a recurrent isochromosome 7q and, less often, trisomy 8,9 but its pathogenesis remains largely unknown.
Despite relatively innocuous cytology, the disease is highly aggressive, with an almost certain fatal outcome and a median overall survival barely exceeding 1 year.4 Occasional long-time survivors have been reported, and few patients respond to cytarabine or deoxycoformycin.4,10 Therapeutic strategies curative in a significant proportion of other aggressive subtypes of lymphoma have proven ineffective in HSTL, and efficient treatment modalities remain to be defined.
Over the past years, genome-wide molecular profiling studies have contributed significant insights into the pathobiology of several T-cell lymphoma entities11-14 and have provided informative data on the multiple molecular subgroups in peripheral T-cell lymphoma, not otherwise specified (PTCL-NOS).15,16 Data on HSTL remain scarce.13,17 In the present study, we analyzed a series of HSTL samples in relation to normal γδ cells, PTCL-NOS, and extranodal NK/T-cell lymphoma, nasal-type (NKTCL), another entity derived from cytotoxic lymphocytes of the innate immune system. The aims of the present study were: (1) to characterize the molecular signature of HSTL, (2) to identify potential candidate pathways relevant to pathogenesis, and (3) to search for biomarkers useful for diagnostic purposes or in the future targeted therapies.
Methods
Patient characteristics and tumor samples
Nine HSTL patients with high-quality RNA and/or DNA extracted from frozen tumor samples were selected for this study. All patients had spleen, liver, and BM involvement without lymphadenopathies. Three patients had been included in previous studies.4,9 The main clinical, phenotypical, and molecular characteristics are summarized in Table 1. The tumor samples comprised 6 splenic tissue samples and 3 cell suspensions (from spleen, BM, and blood), 2 of which were enriched in tumor cells (samples HSTL_01 and HSTL_09). All cases were reviewed by 3 hematopathologists (L.d.L, Y.H., and P.G.) and diagnosed according to WHO criteria.8 The tumor cells had a CD3+, CD2+, CD5−, TiA1+, GzmB− immunophenotype and were negative for EBV. TCR lineage was determined by immunohistochemistry and/or flow cytometry for TCRβ and TCRδ chain expression and by GC-clamp multiplex PCR for TCRγ and/or δ chain rearrangements (the PCRδ–denaturing gradient gel electrophoresis procedure).18 In total, 7 patients with a δTCR1+, βF1− immunophenotype and/or a biallelic rearrangement of the TCRδ chain18,19 were classified as γδ HSTL and 2 patients with a δTCR1−, βF1+ phenotype as αβ HSTL. Four of 7 investigated patients had isochromosome 7q. Twelve additional HSTL cases were selected for validations (10 formalin-fixed tissues for immunohistochemistry and 2 frozen samples for RT-PCR analyses).
The study was approved by the institutional review board Comité de Protection des Personnes Ile de France IX, Créteil, France (number 08-009; June 5, 2008).
Cell lines and normal γδ T cells
Eight samples of normal peripheral blood activated γδ T cells (6 from Correia20 and 2 from Zhang21 ) and 3 samples of normal resting γδ T cells (from Correia20 ) were used for comparison. Normal γδ T cells sorted using a magnetic anti-TCRγ/δ microbeads kit (Miltenyi Biotec) from 3 spleens removed for benign conditions were also obtained for quantitative RT-PCR (qRT-PCR) validation. DERL2, a γδ cell line derived from HSTL,22 was cultured in IMDM supplemented with 2mM l-glutamine and 20% heat-inactivated human serum (Invitrogen) in the presence of recombinant human IL-2 (100 U/mL; Laboratoires Chiron). Centrifuged pellets of DERL2 cells were fixed in ethanol to construct paraffin-embedded blocks.14
Microarray procedures
GEP
For gene-expression profiling (GEP), HG-U133 Plus Version 2.0 Affymetrix array data were obtained from 9 HSTL patients and the DERL-2 cell line (Table 1) and deposited in ArrayExpress under accession number E-MTAB-638. HG-U133 Plus Version 2.0 profiles of 42 PTCL-NOS, 23 angioimmunoblastic T-cell lymphoma (AITL), 23 NKTCL, and 3 HSTL patients described previously by our group (E-TABM-783 and E-TABM-702, n = 40)11,14 and others (GSE19067 and GSE6338, n = 51)12,13 were used for analyses. Control samples (8 activated γδ T cells, 3 resting γδ T cells, 18 B cells, 6 spleens, and 9 lymph nodes) were collected by us (n = 6) or were from public sources (E-MEX-1601, GSE13906, GSE12195, GSE15271, and GSE7307).20,21,23,24 Affymetrix raw data of all samples were normalized in batch using the RMA algorithm. The clustering analysis of the 50 tumor samples from our series was performed as described previously.14 We used moderate t tests to identify genes differentially expressed between 2 groups of samples and area under the curve criteria to identify discriminant genes. KEGG and Biocarta pathways (and related genes) were obtained from ftp://ftp.genome.ad.jp/pub/kegg/pathways/hsa and http://www.biocarta.com, respectively. Pathways were ranked according to the scores of 3 different algorithms, including GlobalTest, SAM-GS, and GSA. Details are provided in supplemental Methods (available on the Blood Web site; see the Supplemental Materials link at the top of the online article).
aCGH
DNAs extracted from 7 HSTL patients and the DERL2 cell line were hybridized on Agilent Sureprint CGH array 4 × 180 k covering more than 170 000 coding and noncoding human sequences. Array-based comparative genomic hybridization (aCGH) raw Cy3/Cy5 intensities were quantile normalized independently for each sample; smoothing was performed using the tiling Array R package. Copy number status (gain/loss) determination in the smoothed segments was done as described previously.14 Details are given in supplemental Methods.
qRT-PCR analysis of candidate genes
The expression level of candidate genes (FOS, FOSB, AIM1, RHOB, ABCB1, VAV3, KIR3DS1, and S1PR5) identified in the GEP analyses was determined by TaqMan qRT-PCR (Applied Biosystems) in 11 primary HSTL tumors (including the 9 cases submitted to GEP analysis), the DERL2 cell line, and 3 normal splenic γδ T-cell samples as a control. All primers and probes were purchased from Applied Biosystems and the gene expression was measured using Mastercycler ep realplex2S system (Eppendorf). Quantifications were done in duplicate and mean values and SDs were calculated for each transcript, as described previously.25
Immunohistochemical analysis of selected candidate genes
Immunohistochemistry was performed on deparaffinized tissue sections using a standard indirect avidin-biotin immunoperoxidase method. After appropriate antigen retrieval, sections were stained for FosB (Cell Signaling Technology); CD56, CD163, and GSTP1 (Novocastra-Leica); β-catenin (BD Biosciences); Bcl-10 (Zymed); ICAM-1 (Atlas Antibodies); VCAM-1 and Syk (Santa Cruz Biotechnology); and Blimp-1 (BioLegend). For Granzyme H (4G5), a tyramide signal amplification system was applied, as described previously.14 Adequate controls were included.
Methylation analysis of AIM1
Two micrograms of genomic DNA was treated with bisulfite using the Epitect Bisulfite Kit (QIAGEN) according to the manufacturer's protocol. Nested bisulfite-specific PCR for the 2 CpG islands of AIM1 (absent in melanoma 1) was performed on DERL2 cells DNA (details, primers, and PCR programs used are given in supplemental Methods). PCR products were cloned in plasmid using the TOPO TA cloning kit for sequencing (Invitrogen). Ten clones for each CpG island were screened and sequenced on the ABI 3130 × 1 genetic analyzer (Applied Biosystems).
5-Aza-2′-deoxycytidine treatment of DERL2 cells
DERL2 cells were treated with the demethylating agent 5-Aza-2′-deoxycytidine (decitabine; Merck Chemicals) at 10 or 40μM for 96 hours (decitabine was added every 24 hours) alone or in combination with 500nM histone deacetylase inhibitor trichostatin A (TSA; Sigma-Aldrich). In the combined treatment (decitabine and TSA), cells were treated every 24 hours with 10 or 40μM decitabine for 96 hours, followed by 500nM TSA for the last 24 hours. Total RNA was extracted and qRT-PCR was performed to evaluate the reexpression of the demethylated gene AIM1 after decitabine treatment. In addition, the number of apoptotic cells was determined by annexin V+ 7-amino-actinomycin D–positive (7AAD+) cells using a cyan flow cytometer (Beckman Coulter).
Immunoblot analysis
Total cell proteins extracted from normal blood T cells purified after CD2 magnetic beads selection and activated or not by CD3 (1 μg/mL), CD28 (1 μg/mL), and IL-2 (100 U/mL); overnight serum deprived DERL2 cells with or without CD3, CD28, and IL-2 activation and overnight serum deprived SUDHL4 cells with or without BCR stimulation (anti-Fab′2, 4 μg/mL) were analyzed for the expression of Syk, phospho-Syk (Tyr525/526; C87C1; Cell Signaling technology), and β-actin (Sigma-Aldrich). Immunoblotting was as described previously.25
Apoptosis assay with a Syk inhibitor
Normal activated γδ T cells were obtained as described previously,26 and DERL2 cells were plated at 1 000 000/well and incubated for 48 hours in the absence or presence of Syk inhibitor II (Merck Chemicals) at 2 different concentrations (40 and 60μM). The number of apoptotic cells was determined by the number of annexin V+7AAD+ cells. For the normal activated γδ T cells, TCRVγ9 apoptotic cells were determined by measuring the percentage of TCRVγ9+ and 7AAD+ cells.
Results
HSTL as a molecularly distinct entity irrespective of TCR γδ or αβ lineage
Unsupervised consensus clustering of the expression profiles of 9 HSTL tumors and 41 additional T-cell lymphoma samples, including PTCL-NOS, AITL, and NKTCL, demonstrated a clear separation between HSTL and other T-cell lymphomas entities. The HSTL cluster comprised 2 subgroups consisting of HSTL tissue samples and HSTL cells (sorted cells and cell line; Figure 1). Interestingly, αβ and γδ HSTL clustered together. One nonhepatosplenic γδ T-cell lymphoma case (PTCL_20) with nodal presentation clustered within the NKTCL branch.
HSTL samples cluster separately to the other T-cell lymphomas irrespective of their αβ or γδ lineage. Unsupervised consensus clustering of GEPs of 9 HSTL, the HSTL cell line, 7 NKTCL, 16 PTCL-NOS, and 17 AITL tumor samples. Core clusters (C1, C2, C3, and C4) are defined as groups of at least 5 samples being co-clustered in at least 8 of the 16 initial partitions (see supplemental Methods). Fisher exact test P values for the association between the core clusters C1/C2/C3/C4 and the sample's annotations (lymphoma type, material type, and TCR type) are shown in red. Lymphoma types: H indicates HSTL; N, NKTCL; A, AITL; and P, PCTL-NOS. Material types: C indicates cell line; S, sorted tumor cells; and T, tissue sample. TCR types: A indicates α-β; G, γ-δ.
HSTL samples cluster separately to the other T-cell lymphomas irrespective of their αβ or γδ lineage. Unsupervised consensus clustering of GEPs of 9 HSTL, the HSTL cell line, 7 NKTCL, 16 PTCL-NOS, and 17 AITL tumor samples. Core clusters (C1, C2, C3, and C4) are defined as groups of at least 5 samples being co-clustered in at least 8 of the 16 initial partitions (see supplemental Methods). Fisher exact test P values for the association between the core clusters C1/C2/C3/C4 and the sample's annotations (lymphoma type, material type, and TCR type) are shown in red. Lymphoma types: H indicates HSTL; N, NKTCL; A, AITL; and P, PCTL-NOS. Material types: C indicates cell line; S, sorted tumor cells; and T, tissue sample. TCR types: A indicates α-β; G, γ-δ.
On supervised analysis, αβ and γδ HSTL appeared to have a highly similar gene signature. As illustrated in supplemental Figure 1, a similar level of transcripts of NK-cell–associated molecules, including killer immunoglobulin-like receptors (KIRs), was found in HSTL, irrespective of αβ or γδ lineage. In addition to the genes coding for the γδ and αβ TCR, which, as expected, were the most differentially expressed in both groups, only a small proportion of genes were overexpressed (eg, LCK, SYT11, BCL2L11, and KLRC1) or down-expressed (eg, CR1, TMPRSS3, and ITGA9) in γδ HSTL compared with αβ HSTL (supplemental Table 1). Comparison of HSTL GEPs with those of either PTCL-NOS or NKTCL revealed similar proportions of differentially expressed genes (see “H1 Proportion” in supplemental Methods) of 37% and 39%, respectively. However, in unsupervised clustering analysis, HSTL profiles appeared to be closer to that of NKTCL, another extranodal entity derived from cytotoxic cells, than to that of PTCL-NOS and AITL.
Compared with both PTCL-NOS and NKTCL, several T cell–associated transcripts encoding the γδ TCR subunit were among the top genes overexpressed in HSTL. Two of the genes found to be up-regulated in HSTL were S1PR5, a gene known to be involved in the homing of NK cells into the spleen,27 and ABCB1, a gene encoding for the p-glycoprotein multidrug transporter (MDR1). These findings were confirmed by qRT-PCR demonstrating high S1PR5 and ABCB1 transcripts in HSTL compared with PTCL-NOS and NKTCL (Figure 2). Genes encoding KIRs and other NK-cell–associated molecules (eg, NCAM1 and CD244) were specifically overexpressed compared with PTCL-NOS (Tables 2 and 3).
Validation of selected genes by qRT-PCR analysis. qRT-PCR analysis for S1PR5, ABCB1, FOS, FOSB, RHOB, VAV3, and KIR3DS1 in HSTL tissues (n = 10), cells (n = 3), PTCL-NOS (n = 14), and NKTCL (n = 6). The results are expressed as the relative fold change compared with normal γδ T cells sorted from spleen. Values for each sample were normalized to GAPDH. An arbitrary value of 1 was assigned to normal γδ T cells.
Validation of selected genes by qRT-PCR analysis. qRT-PCR analysis for S1PR5, ABCB1, FOS, FOSB, RHOB, VAV3, and KIR3DS1 in HSTL tissues (n = 10), cells (n = 3), PTCL-NOS (n = 14), and NKTCL (n = 6). The results are expressed as the relative fold change compared with normal γδ T cells sorted from spleen. Values for each sample were normalized to GAPDH. An arbitrary value of 1 was assigned to normal γδ T cells.
AIM1, reported as a tumor-suppressor gene,28 was underexpressed in HSTL compared with both PTCL-NOS and NKTCL. The genes underexpressed in HSTL compared with PTCL-NOS included genes encoding TFH-associated molecules (eg, CXCL13, ICOS, CD200, and CXCR5), others involved in immunomodulation (eg, IDO1 and IL4I1), and CD5, a T-cell surface antigen known to be absent in HSTL cells.
Candidate genes relevant to HSTL pathogenesis
To search for candidate genes relevant to the pathogenesis of HSTL, we compared the HSTL signature with that of normal γδ T cells. A selection of significantly overexpressed and underexpressed genes distinguishing HSTL from normal activated or resting γδ T cells is summarized in Table 4 (P < .01). Among the most overexpressed genes in HSTL were those related to NK-cell–associated molecules, such as KIRs, KLR, CD244, and NCAM1. The other overexpressed genes were related to oncogenes (eg, FOS, VAV3, MAF, and BRAF), cell adhesion (eg, VCAM1, CD11d, and ICAM1), tyrosine kinases (eg, SYK), signal transduction (eg, SPRY2, RHOB, MAP4K3, and SPRY1), the sonic hedgehog pathway (eg, GLI3, PRKAR2B, PRKACB, and PRKAR1A), the WNT pathway (eg, FRZB, TCF7L2, BAMBI, TLE1, CTNNB1, APC, and FZD5), and S1PR5. Interestingly, many of these genes also appeared to be overexpressed in HSTL-sorted cells compared with normal activated or resting cells γδ T cells (supplemental Table 1). This was the case for genes encoding FOS, VAV3, RHOB, S1PR5, and NK-cell–associated molecules, indicating that their overexpression could be attributed to the neoplastic cells. These findings were confirmed by qRT-PCR analysis (Figure 2) demonstrating overexpression of FOS, RHOB, VAV3, S1PR5, and KIR3DS1 mRNAs in HSTL-sorted cells, and to a lesser extent in HSTL tissues, compared with normal γδ T cells. Furthermore, another oncogene, FOSB (belonging to the AP1 family), was overexpressed in HSTL cells compared with activated γδ T cells. This finding was corroborated by qRT-PCR analysis (Figure 2D) and by immunohistochemistry showing the presence of FosB-positive cells coexpressing CD2 or TIA1 in HSTL (Figure 3A and Table 5). In addition, membrane CD56 (9/17) and cytoplasmic Syk (8/9) were demonstrated in the neoplastic cells infiltrating the sinuses in the spleen or BM (Figure 3C-D and Table 5).
Validation of genes overexpressed in GEP by immunohistochemistry. Representative HSTL disclosed staining of neoplastic cells for FOSB (A), SYK (B), CD56 (C), BCL10 (D), GSTP1 (E), and PRDM1 (F-G). Panel G shows DERL2 cells. The inset of panel A illustrates FOSB-positive cells (brown) also expressing TIA1 (red). Staining of scattered reactive cells positive for granzyme H is seen (H). Images were captured with a Zeiss Axioskop2 microscope (Zeiss). Photographs were taken with an Olympus DP70 camera. Images were acquired with Olympus DP Controller 2002 and images were processed with Adobe Photoshop Version 7.0. Original magnification, 400× (A-H).
Validation of genes overexpressed in GEP by immunohistochemistry. Representative HSTL disclosed staining of neoplastic cells for FOSB (A), SYK (B), CD56 (C), BCL10 (D), GSTP1 (E), and PRDM1 (F-G). Panel G shows DERL2 cells. The inset of panel A illustrates FOSB-positive cells (brown) also expressing TIA1 (red). Staining of scattered reactive cells positive for granzyme H is seen (H). Images were captured with a Zeiss Axioskop2 microscope (Zeiss). Photographs were taken with an Olympus DP70 camera. Images were acquired with Olympus DP Controller 2002 and images were processed with Adobe Photoshop Version 7.0. Original magnification, 400× (A-H).
Genes associated with cytotoxicity (eg, Granulysin, Granzyme H, Granzyme K, and Granzyme B), cytokines (eg, LTA, TNF, and IFNG), the tumor suppressor AIM1, and CD5 were among those genes significantly underexpressed in HSTL compared with their normal cell counterparts. The absence of expression of cytotoxic molecules such as Granzyme B (Table 1) and Granzyme H was shown by immunostaining (Figure 3H and Table 5), whereas the dramatic reduction of AIM1 transcripts was demonstrated by qRT-PCR in both HSTL tissues and sorted cells compared with normal γδ cells.
Biomarkers discriminating HSTL from other lymphomas and normal controls
Expression of several genes in the molecular signature of HSTL appeared most likely to be attributed to the normal spleen signature. This was the case for the ICAM-1, VCAM-1, and CD163 gene products, the expression of which was shown by immunohistochemistry to be restricted to nonneoplastic cells; that is, endothelial cells (VCAM1 and ICAM1) and macrophages (CD163). To build a biomarker list differentiating HSTL from other T-cell lymphoma entities and eliminating the observed microenvironmental signature, supervised tests (see supplemental Methods for details) were performed between HSTL and other lymphomas (ie, AITL, PTCL-NOS, and NKTCL), between HSTL and control samples (ie, normal lymph nodes, spleen, γδ T cells, and B cells), and between HSTL obtained from tissues and cell suspensions. This yielded a list of 54 genes distinguishing HSTL from other lymphoma entities and normal controls (supplemental Figure 2 and supplemental Tables 2-4). Among these 54 genes were those encoding KIR molecules (KIR3DS1), CD244, DTNBP1, and S1PR5. The application of this list of biomarkers to an independent series of lymphoma samples (including 4 HSTL, 15 AITL, and 11 PTCL-NOS samples) using a different platform17 allowed the discrimination of HSTL from other PTCLs (supplemental Figure 3).
Relevant pathways and genes potentially involved in HSTL resistance to therapy
Pathway analyses showed significant enrichment of several pathways that are involved in cancer development or that can be the target of innovative treatments, such as VEGF, MAPK, JAK-STAT, mTOR, Notch signaling pathways, cytokine-cytokine receptor interaction, and cell adhesion (Table 6 and supplemental Table 5). The Wnt signature was found to be deregulated, but activation of the pathway was not supported by immunohistochemistry because the expression of β-catenin was restricted to endothelial cells. Consistent with previous findings,17 pathways related to NK-cell–mediated cytotoxicity were among the most differentially expressed compared with other T-cell lymphoma entities and normal γδ T cells (Figure 4A). Furthermore, as illustrated in Figure 4B, many genes in the TCR signaling pathway (eg, VAV3 and BCL10) that were linked to the AP1 pathway (eg, FOS) were enriched in HSTL compared with PTCL-NOS and NKTCL. These finding were supported by the high levels of VAV3, FOS, and FOSB transcripts demonstrated by qRT-PCR and by immunohistochemical detection of Bcl-10 in the neoplastic cells of all investigated HSTL samples (5 of 5; Figure 3D and Table 5). Significant enrichment of genes in the pathways of Sprouty regulation of tyrosine kinase and the Sonic Hedgehog signaling, such as genes for the composition of cAMP-dependent kinase (eg, PRKAR2B, PRKAR1A, and PRKACB), the transcription factor Ci (eg, GLI3), the receptor patched (PTCH1), and GSK3B, were found in HSTL (Figure 4). Interestingly, several genes in the multidrug resistance signaling pathways (eg, ABCB1 and GSTP1) were enriched in HSTL (Figure 4E) compared with PTCL-NOS and NKTCL and PRDM1, another gene reported to be associated with resistance to therapy in PTCLs.29 High levels of ABCB1 transcripts were confirmed by qRT-PCR (Figure 2B), and expression of GSTP1 and Blimp-1 was demonstrated by immunohistochemistry in the HSTL cells of all evaluated cases, as well as in DERL2 cells (Figure 3). As illustrated in Figure 4F, HSTL cells were closer to activated γδ T cells than resting γδ T cells with respect to the expression of cell-cycle–related genes.
Cellular programs deregulated in HSTL. Asterisks show resting γδ T cells. Representative molecular pathways, among those differentially expressed (as shown by enrichment analysis, see Table 6 and supplemental Table 5) in HSTL by comparison with NKTCL, PTCL-NOS, and normal γδ T cells, are illustrated. (A) NK-cell–mediated cytotoxicity. (B) TCR signaling pathway. (C) Sprouty regulation of the tyrosine kinase signal pathway. (D) Sonic hedgehog pathway. (E) Multidrug resistance factors. (F) Cell cycle. For each line, green corresponds to the minimal intensity value (min), red corresponds to the maximal intensity value (max), and black corresponds to (max − min)/2.
Cellular programs deregulated in HSTL. Asterisks show resting γδ T cells. Representative molecular pathways, among those differentially expressed (as shown by enrichment analysis, see Table 6 and supplemental Table 5) in HSTL by comparison with NKTCL, PTCL-NOS, and normal γδ T cells, are illustrated. (A) NK-cell–mediated cytotoxicity. (B) TCR signaling pathway. (C) Sprouty regulation of the tyrosine kinase signal pathway. (D) Sonic hedgehog pathway. (E) Multidrug resistance factors. (F) Cell cycle. For each line, green corresponds to the minimal intensity value (min), red corresponds to the maximal intensity value (max), and black corresponds to (max − min)/2.
Isochromosome 7q is the main recurrent genomic aberration in HSTL
The aCGH findings confirmed recurrent isochromosome 7q in 4 of the 7 tested cases (60%), with only few other alterations comprising trisomy 8, as described previously,9 loss of the 10p arm and more focal alterations (−14q,+15q, −18q −21q, and −22q) in 2-6 cases (30%-85%; supplemental Figure 4). To determine whether iso7q affects the molecular signature, we analyzed the mean expression of genes located on the 7p and 7q arms for each sample (supplemental Figure 5). This analysis clearly showed overexpression of 7q and down-expression of 7p genes in all cases with the iso7q aberration as well as in 2 additional cases (HSTL_08 and HSTL_09) for which the iso7q status was unknown (due to the absence of aCGHa and FISH data), one of which was shown subsequently to be iso7q by FISH (HSTL_09). To identify potential candidate genes involved in iso7q, we also compared the expression level of iso7q+ HSTL cases with normal controls (ie, activated γδ T cells). Among the most repressed genes on the 7p arm were CYCS and IKZF1, which are associated with regulation of apoptosis, and HUS1 and CBX3, which are involved in DNA repair, whereas the most overexpressed genes on the 7q arm included the putative oncogene PTPN12 (supplemental Table 1). Moreover, pathway analysis comparing iso7q+ HSTL with activated or resting γδ T cells showed a significant enrichment of apoptosis-related pathways (supplemental Table 5).
AIM1 is methylated in HSTL
AIM1, initially described as a tumor-suppressor gene deleted in melanoma, was subsequently found to be deregulated in NKTCL.28,30 In the present study, we show significant down-expression of AIM1 mRNA in HSTL and DERL2 cells. Low levels of AIM1 mRNAs were confirmed by qRT-PCR in HTSL primary tumors and in DERL2 cells compared with normal γδ T cells (Figure 4A). We also searched for genetic alterations underlying AIM1 down-regulation. In the absence of genomic imbalance in the AIM1 locus at 6q21 in the aCGH data, we wondered whether AIM1 down-regulation in HSTL could be the result of methylation, as was reported previously in other hematologic malignancies such as myeloma and NKTCL.30,31 The promoter methylation status of AIM1 was analyzed in the HSTL-derived cell line DERL-2. Sequencing of AIM1 on bisulfite-treated DNA revealed methylation in both CpG islands (Figure 5B). Furthermore, treatment of DERL2 cells containing the AIM1-methylated promoter with the DNA demethylating agent decitabine with or without TSA resulted in a 2- to 3-fold increase in the AIM1 mRNA level compared with untreated cells, supporting the idea that AIM1 down-expression in HSTL could be reversed by demethylation (Figure 5C). Interestingly, the number of DERL2 apoptotic cells was increased after decitabine treatment (Figure 5D).
AIM1 is methylated in the DERL2 HSTL cell line. (A) Real-time PCR quantification of AIM1 was evaluated innormal γδ T cells, HSTL tissues, HSTL cells, DERL2 cells, PTCL-NOS, and NKTCL. The results are expressed as the relative fold change compared with normal γδ T cells sorted from the spleen. Each sample was normalized to GAPDH. (B) Localization of CpG islands (CpG1 and CpG2) in the AIM1 promoter and schematic representation of the sequenced genomic fragments including all CpG sites (vertical bars). Approximate spacing of the CpG dinucleotides is shown for the 44 CpGs of island 1 and the 119 CpGs of island 2 (top). Ten representative clones from DERL2 cells are presented, only 43 CpGs of island 2 were represented because of unmethylation of the first 76 CpGs (left). Example of methylated cytosines after bisulfite-converted genomic DNA treatment (right). (C) Real-time PCR quantification of AIM1 was evaluated in DERL2 cells after 96 hours of 10 or 40μM decitabine treatment (every 24 hours) with or without 500nM TSA treatment for the last 24 hours. (D) DERL2 cells were cultured with or without 10 or 40μM decitabine for 96 hours (decitabine was added every 24 hours). Cellular apoptosis was analyzed using 7AAD staining.
AIM1 is methylated in the DERL2 HSTL cell line. (A) Real-time PCR quantification of AIM1 was evaluated innormal γδ T cells, HSTL tissues, HSTL cells, DERL2 cells, PTCL-NOS, and NKTCL. The results are expressed as the relative fold change compared with normal γδ T cells sorted from the spleen. Each sample was normalized to GAPDH. (B) Localization of CpG islands (CpG1 and CpG2) in the AIM1 promoter and schematic representation of the sequenced genomic fragments including all CpG sites (vertical bars). Approximate spacing of the CpG dinucleotides is shown for the 44 CpGs of island 1 and the 119 CpGs of island 2 (top). Ten representative clones from DERL2 cells are presented, only 43 CpGs of island 2 were represented because of unmethylation of the first 76 CpGs (left). Example of methylated cytosines after bisulfite-converted genomic DNA treatment (right). (C) Real-time PCR quantification of AIM1 was evaluated in DERL2 cells after 96 hours of 10 or 40μM decitabine treatment (every 24 hours) with or without 500nM TSA treatment for the last 24 hours. (D) DERL2 cells were cultured with or without 10 or 40μM decitabine for 96 hours (decitabine was added every 24 hours). Cellular apoptosis was analyzed using 7AAD staining.
Syk as a candidate target for pharmacologic inhibition in HSTL
Whereas normal mature T lymphocytes lack Syk expression, the Syk protein has been recently reported to be aberrantly expressed in many PTCLs.32 In the present study, GEP analysis revealed overexpression of SYK mRNA in HSTL tissues, in HSTL-sorted cells, and in the DERL2 cell line compared with normal γδ T cells (Figure 6A). We also demonstrated Syk expression by neoplastic HSTL cells and DERL2 cells using immunohistochemistry and Western blot (Figure 3B, Table 5, and Figure 6B-C). Because the expression of Syk does not provide information on its activity, we analyzed the phosphorylation status of Syk in DERL2 cells using a phosphospecific anti-Syk (Tyr525/526) Ab. Syk was constitutively activated in DERL2 cells (Figure 6C). However, the mechanism leading to Syk activation is unclear because neither SYK amplification nor ITK-SYK fusion was detected by FISH analysis in DERL2 cells (data not shown). To determine whether Syk could contribute to the growth and survival of neoplastic HSTL cells, a chemical anti-Syk agent was used to inhibit Syk activity in DERL2 cells. Syk inhibition induced an significant increase in apoptosis in a dose-dependent manner in the DERL2 cell line compared with normal activated γδ T cells (Figure 6D).
SYK is a potential candidate target for pharmacologic inhibition. (A) Histogram representation of Affymetrix data of overexpressed SYK probe set in HSTL tissues, HSTL cells, normal γδ T cells, and DERL2 cells. (B) Immunostaining of SYK in the DERL2 cell line. (C) Western blot analysis of Syk, phosphorylated Syk tyr525/526, and loading control β actin. (D) DERL2 cells or normal activated γδ T cells were cultured with 40 or 60μM Syk inhibitor II or vehicle alone for 48 hours. Apoptosis was analyzed using 7AAD staining. For normal activated γδ T cells, TCRVγ9 apoptotic cells were determined by measuring the percentage of TCRVγ9+ and 7AAD+ cells. *P < .05.
SYK is a potential candidate target for pharmacologic inhibition. (A) Histogram representation of Affymetrix data of overexpressed SYK probe set in HSTL tissues, HSTL cells, normal γδ T cells, and DERL2 cells. (B) Immunostaining of SYK in the DERL2 cell line. (C) Western blot analysis of Syk, phosphorylated Syk tyr525/526, and loading control β actin. (D) DERL2 cells or normal activated γδ T cells were cultured with 40 or 60μM Syk inhibitor II or vehicle alone for 48 hours. Apoptosis was analyzed using 7AAD staining. For normal activated γδ T cells, TCRVγ9 apoptotic cells were determined by measuring the percentage of TCRVγ9+ and 7AAD+ cells. *P < .05.
Discussion
HSTL is a rare and distinct PTCL entity of unknown pathogenesis. The disease is characterized by a peculiar distribution of the neoplastic cells, most often of γδ T-cell derivation, within the sinuses of the spleen, liver, and BM and by a clinically fatal outcome. Previous scarce reports showed that HSTL has a distinct gene signature.13,17 Taking advantage of the exceptional availability of samples enriched in tumor cells, we showed herein by consensus clustering that HSTL expression profiles clustered in a single branch independently of the spleen, BM, or blood origin of the diagnostic samples, indicating that this signature is independent of the microenvironment. The distinct signature was further confirmed when a gene list was constructed by eliminating the signature of the normal spleen and lymph nodes. HSTL was initially reported as being of γδ T-cell derivation, but similar cases with a αβ phenotype have since been reported.
In the present study, we show that 2 cases of HSTL with a αβ phenotype had a gene signature and a genomic profile that were very similar to the classic γδ HSTL variant, providing strong molecular arguments for grouping γδ and αβ HSTL as a single entity, as was proposed in the current WHO classification.8 The similar αβ and γδ HSTL molecular signature was largely contributed by genes implicated in cytotoxic T- and NK-cell function and development, suggesting that both αβ and γδ variants are derived from subsets of cells of the innate immune system.8,33,34 Indeed, a subset of αβ T cells, referred as NKT cells, share characteristics with NK cells and γδ T cells (including expression of CD161 (KLRB1), CD16, CD56, and KIR molecules) and participate with NK cells and γδ T cells in the innate immune system.35 γδ T cells can accumulate in immunosuppressed patients and in the setting of chronic antigen stimulation. Expansion of γδ T cells has been reported particularly in patients after kidney transplantation, systemic lupus, Hodgkin lymphoma, or malaria4 and, more recently, also after treatment with anti-TNF agents.36
The elective distribution of neoplastic cells within the sinuses and sinusoids of the BM, spleen, and liver is remarkable and accounts for the peculiar clinical presentation of HSTL with hepatosplenomegaly and cytopenia but without lymphadenopathy and leukemia. Interestingly, one of the genes with the highest change of expression compared with PTCL-NOS and NKTCL and, to a lesser extent, normal γδ T cells, was sphingosine-1-phosphatase receptor 5 (S1PR5). S1PR5 encodes a member of the family of S1P receptors known to be involved in T- and B-cell exit from lymphoid organs.37 S1PR5 is preferentially expressed by mature CD56dim human NK cells38 and is involved in NK-cell trafficking in steady-state and inflammatory situations. It has been reported that S1PR5-deficient mice have defective homing of NK cells to the blood and spleen.27,38 Although the role of S1PR5 in γδ T cells is uncharacterized, the high level of S1PR5 mRNA in HSTL might explain the peculiar distribution and accumulation of neoplastic γδ cells in the spleen and BM, preventing tumor cells from exiting sinusoids. Whether cell-cell interactions involving the cell adhesion molecule LFA1 (CD11a), which is expressed by HSTL cells, and VCAM1, which is expressed by splenic sinusoidal cells, could also play a role in the clinicopathologic picture of the disease remains to be determined.
Although our GEP findings were based on the comparison with normal blood γδ T cells and not with splenic γδ T cells, the down- or overexpression of selected genes compared with normal splenic γδ T cells was validated by qRT-PCR. From the results of the present study, it appears that several candidate genes involved in distinct pathways (ie, TCR signaling, cell cycle, sonic hedgehog, sprouty regulation of tyrosine kinase pathways, and multidrug resistance) could potentially be associated with the pathophysiology of HSTL. One of the genes we found to be overexpressed in HSTL is MDR-1, the expression of which was significant for this lymphoma compared with normal γδ T cells, PTCL-NOS, and NKTCL. The P-glycoprotein (P-gp), encoded by MDR-1, is able to export drugs out of the cytoplasm, thus reducing the intracellular accumulation of cytotoxic drugs. P-gp has been reported to be overexpressed and associated with poor outcome in various hematologic malignancies including NKTCL and diffuse large B-cell lymphoma (DLBCL).39-41 Interestingly, sensitivity to aracytine is not influenced by P-gp overexpression in multidrug resistant cell lines.42 Although HSTL is reported as a fatal disease, recent studies have described long-time survivors after cytarabine-based chemotherapy.4 The present findings might provide a rationale for the use of cytarabine-containing regimens in HSTL. In addition to P-gp expression, we have also demonstrated that GST, another molecule involved in resistance to alkylating agents and anthracyclines,43 was also expressed by the neoplastic HSTL cells (as shown by immunohistochemistry). One could hypothesize that the combination of P-gp and GST-π expression might contribute to the resistance of HSTL to anthracycline-based chemotherapy regimens and thus to its poor outcome. High levels of GST-π are present in the neoplastic cells of mantle cell lymphoma and DLBCL44,45 and are correlated with poor prognosis in DLBCL.44 The role of the transcription factor Blimp-1 in PTCL is unclear. In the present study, we show that PRDM1 is expressed at the mRNA and protein levels in HSTL cells. Whereas inactivation of PRDM1 through epigenetic mechanisms has been reported recently in NKTCL, suggesting a role as tumor-suppressor gene,30,46 its expression has been associated with chemoresistance in T-cell lymphoma.29
Tumor development is a multistep process involving deregulation of oncogenes and tumor suppressor genes (TSGs). To date, no oncogene or TSG has been identified in HSTL. AIM1 is a gene with expression that has been shown to be altered in association with tumor suppression in a model of human melanoma.28 It is frequently deleted or methylated in several solid tumors and in myeloma and, more interestingly, in NK cell lines.14,30,31 These previous data and our present findings that AIM1 is reduced dramatically in HSTL, most likely because of promoter methylation, suggest that AIM1 might play a role as a TSG in HSTL oncogenesis and provide the rationale for testing demethylating agents in this disease. Our expression data also suggest that the recurrent iso7q aberration in HSTL could target putative TSG and oncogenes, including IKZF1 and PTPN12.
With respect to potential targets for novel therapies in HSTL, we also demonstrated Syk expression by neoplastic HSTL cells with constitutive activation in DERL2 cells compared with normal T cells. Syk is a protein tyrosine kinase involved in BCR signaling, and its activation is associated with cell growth and survival in B-cell lymphomas.47,48 Normal mature T lymphocytes lack Syk expression.49 However, the Syk protein has been reported recently as a feature common to most PTCLs; this may represent a novel therapeutic target, because, in addition to its aberrant expression in many PTCLs, inhibition of Syk induces apoptosis and blocks proliferation in T-cell lymphoma cell lines.32,49 An orally available Syk inhibitor is currently being tested for B-cell lymphomas in a phase 1/2 clinical trial, with encouraging results.50 In view of the present findings that Syk inhibition induced apoptosis in DERL2 cells in a dose-dependent manner, Syk could also be a potential candidate target for pharmacologic inhibition in HSTL.
In conclusion, the results of the present study show that the distinctive molecular signature of HSTL partly reflects the ontogeny and might explain several clinicopathologic features of the disease, including homing to the sinusoids of the spleen and BM. Our study highlights emerging oncogenic pathways that may be implicated in the pathophysiology of the disease and may offer a rationale for exploring new therapeutic options such as tyrosine kinase inhibitors and demethylating agents in these patients. Finally, this study also provides additional molecular arguments for grouping αβ and γδ HSTL as a single distinct entity.
The online version of this article contains a data supplement.
The publication costs of this article were defrayed in part by page charge payment. Therefore, and solely to indicate this fact, this article is hereby marked “advertisement” in accordance with 18 USC section 1734.
Acknowledgments
The authors thank Christelle Thibault from the Institut de Génétique et de Biologie Moléculaire et Cellulaire platform (Affymetrix: Philippe Kastner); Joe A. Trapani for providing granzyme H Ab; L. Del Vecchio for providing the DERL2 cell line; Jean Jacques Fournié for providing BrHPP; Francois Radvanyi for critical opinions on data interpretation; Jérôme Cuvillier and Nadine Vailhen from Groupe d'Etude des Lymphomes de l'Adulte-Pathologie; and Virginie Fataccioli and Maryse Baia for technical assistance.
This work is part of the Carte d'Identité des Tumeurs program (http://cit.ligue-cancer.net/index.php/en) from the Ligue Nationale Contre le Cancer and of the Tenomic project supported by a Programme Hospitalier de Recherche Clinique and the Institut National du Cancer. This work was supported by Inserm, the Institut National du Cancer, the Plan Cancer of the Belgian government, and the Association pour la Recherche Thérapeutique, Génétique et Immunologique dans les Lymphomes. M.T. was supported by the Fondation pour la Recherche Médicale (DEQ 2010/0318253).
Authorship
Contribution: M.T., Y.H., N.M.-G., J. Bosq, T.M., P.G., and A.d.R. performed the research; M.T., A.d.R., and P.G. analyzed and interpreted the data; M.T., L.d.L., and P.G. designed the research; L.d.L., J. Bosq, J. Brière, M.-H.D.-L., F.B., J.S., E.M., and P.G. collected the data and/or tumor samples; A.d.R. and P.G. and supervised the bioinformatics analyses; T.M. contributed vital analytical tools; and M.T., L.d.L., A.d.R., and P.G. wrote the manuscript.
Conflict-of-interest disclosure: The authors declare no competing financial interests.
Correspondence: Philippe Gaulard, MD, Département de Pathologie and Inserm U955, Hôpital Henri Mondor, 94010 Créteil, France; e-mail: philippe.gaulard@hmn.aphp.fr.
References
Author notes
A.d.R. and P.G. contributed equally to this work.